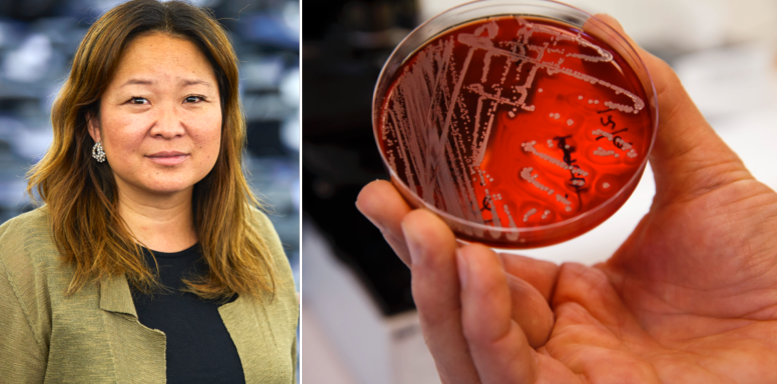

Åtta nya M-förslag i kamp mot antibiotikaresistens
Moderaterna presenterar åtta nya förslag i kampen mot antibiotikaresistens, skriver partiet i ett pressmeddelande. Partiet vill bland annat skärpa regelverket för människors användande och verka för att utveckla ny antibiotika.
Frågan beskrivs som ”en av vår tids stora ödesfrågor” och partiet vill att EU-samarbetet kan användas för att lösa den.
– Eftersom bakterier inte förhåller sig till nationsgränser behöver vi agera gemensamt, säger EU-parlamentarikern Jessica Polfjärd till Europaportalen.
Omni är politiskt obundna och oberoende. Vi strävar efter att ge fler perspektiv på nyheterna. Har du frågor eller synpunkter kring vår rapportering? Kontakta redaktionen



